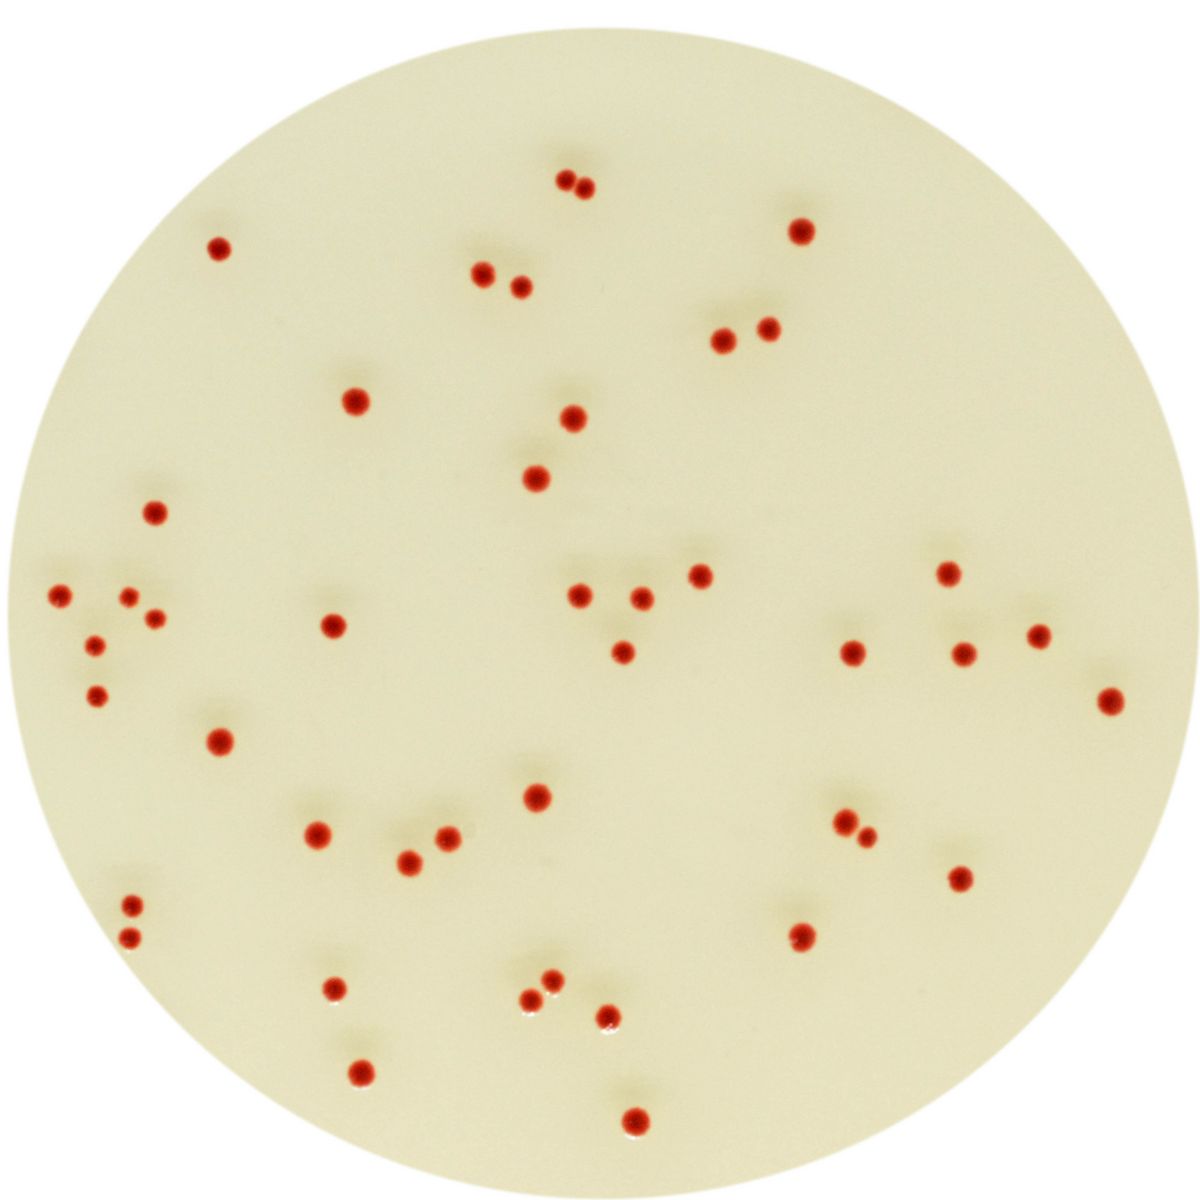

CP573-25
For Detection of thermotolerant Campylobacter
Package size: 25 L
DKK 13.125,00
DKK 3.000,00
Not in stock, delivery 1-2 weeks
Chromogenic medium for detection, differentiation and enumeration of thermotolerant Campylobacter.
The product is composed of a powder base (B) and 1 supplement (S).
MEDIUM PERFORMANCE:
1. In accordance to ISO 10272-1 requirements, as a selective medium for the detection of Campylobacter
2. Easy reading: 36-48 h incubation at 42 °C. The intense red colored colonies on a translucent agar facilitates the reading compared to charcoal based agar.
3. Hige recovery rate: ~100 % enumerating Campylobacter has never been so simple and so reliable.
4. Highly selective: A reinforced selectivity allows for a very clean plate, even with heavily flora loaded samples.
TYPICAL APPEARANCE OF MICROORGANISMS:
Campylobacter jejuni, coli, lari → red
OtherBacteria → blue or inhibited
Campylobacter spp. are fastidious bacteria that may be difficult to recover due to suboptimal specimen transport and/or storage conditions and lack of proper culture procedures. Several culture media formulations have been developed, some blood-based other including charcoal. Each of these media have shown to be a mediocre compromise between specificity and sensitivity.
CHROMagar™ Campylobacter allies the highly specific and easy to read chromogenic technology with an unrivalled growth agar base.
Also availabe in 25 L (CP573-25).